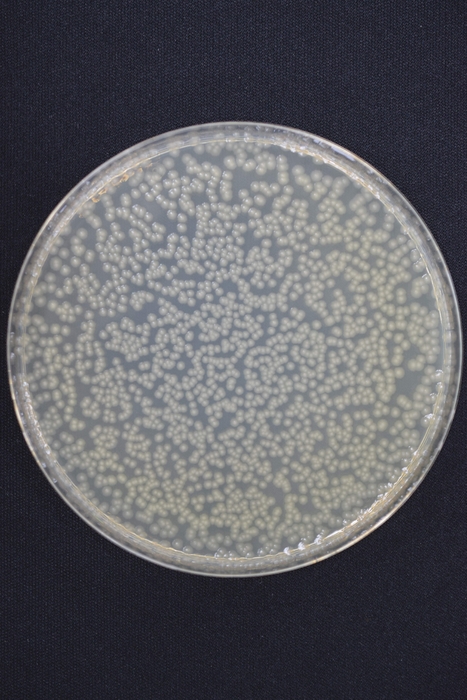

工学院大学研究成果を活用して開発されたオゾン水生成装置が、 ノーリツの最新給湯器に搭載。 ふろ配管を除菌し、排水口に溜まる水のニオイも抑制。
工学院大学(学長:伊藤 慎一郎、所在地:東京都新宿区/八王子市)の岡田 文雄 研究員による研究成果を活用して開発されたオゾン水生成装置が、株式会社ノーリツ(本社:神戸市、代表取締役社長:腹巻 知、資本金:201億円、東証プライム上場)の高効率ガスふろ給湯器GT-C72シリーズに搭載され、2023年7月3日から販売されています。

写真提供 株式会社ノーリツ
オゾン水とは、水にオゾン(03)を溶け込ませた、除菌力の高い液体です。これまでも一部の医療機関や電子部品工場などで使われてきましたが、オゾンガスの放散が避けられない点から、家庭で使う小型機器への導入は進んでいませんでした。岡田研究員は、この課題に対して、ガス溶解性能が高く、オゾンガスを完全に水中へ溶解する水電解装置を組み上げることで解決し搭載が決まりました。小型、省電力といった特徴があり、株式会社ノーリツによる菌の不活化試験では99%の不活化率を確認しました。
新製品 高効率ガスふろ給湯器GT-C72シリーズ 概要
商品名 : ふろ給湯器GT-C72PWA シリーズ 6種類展開
販売開始: 2023年7月3日
販売価格: 524,150円 - 600,380円(税込)
商品詳細: ノーリツ ニュースリリース(商品情報) 2023年4月5日発表
https://www.noritz.co.jp/company/news/2023/20230405-005231.html

写真提供 株式会社ノーリツ
岡田 文雄 研究員のコメントと技術解説
足掛け20年間にわたる研究成果の一部が商品に採用されて社会貢献ができ、大変光栄です。低濃度のオゾン水は、髪の毛や食べ物カス等の固形物は分解不可ですが、ふろ配管内を除菌し、ぬめりの発生や入浴水のニオイを抑制するので、お風呂の清掃が手軽に短時間で済み衛生環境の改善が期待できます。
研究室では、より高濃度な0.5mg/Lのオゾンと0.2mg/Lの過酸化水素を共含する殺菌洗浄水を4L/minの流量で生成する小型水電解装置も作製済みです(写真・上)。この装置は、大腸菌及びネコカリシウイルス(ノロウイルスの代替ウイルス)を99.99%以上不活化できるので、病院等の医療機関や介護施設での利用にも適します。実験結果の一例として、八王子キャンパス付近を流れる川口川の水を流して電解した結果、水道水レベルまで殺菌することを確認しました。水道水と家庭用電源(100V)のみで無尽蔵に殺菌洗浄剤を生成し、一般家庭でも手軽に低コストで殺菌洗浄ができます。
私は、安全なオゾン水を大流量で生成する大型装置にも取り組んでいます。水電解方式で85L/min(写真・中央)、放電式オゾナイザー方式で120L/min(写真・下)のオゾン水を製造できるようになりました。これらの大型装置もオゾンガスを放散しないため安全で、食品や半導体工場の製造ライン、プール、大浴場、農場、養魚場、畜産場などでの殺菌、洗浄、排水処理に最適な技術です。
これらの技術は、人手不足の解消やエネルギー・用役費の節減のみならず、社会の安心と安全に寄与します。



参考:工学院大学について
工学院大学は日本の工科系私立大学、1887年設立。キャンパスは東京都新宿区と八王子市。先進工学部、工学部、建築学部、情報学部および大学院を設置。モノづくりの現場でリーダーとなる人材を育成し続けている。技術移転に積極的で、2021年から特許事務所に一部業務を委託し、適合率が向上している。